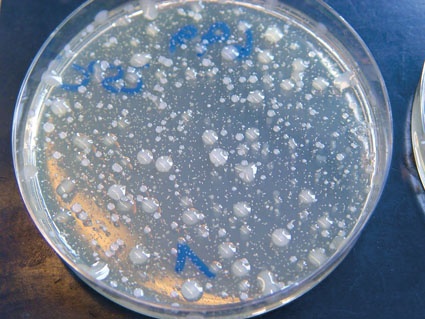
Keime bilden Kolonien, die sich zu einem schleimartigen Biofilm verbinden...

Trinkwasserinstallationen in Krankenhäusern: Den Keimen keine Chance
Trinkwasserinstallationen in Krankenhäusern sind sensible Bereiche. Richtige Planung und Wartung sind daher von enormer Bedeutung, weiß die Initiative Blue Responsibility. Eine aktuelle Studie des Biofilm Centre der Universität Duisburg Essen hat es jüngst an den Tag gebracht: Die Trinkwasserleitungen öffentlicher Gebäude, zu denen auch Krankenhäuser zählen, sind weitaus häufiger von gesundheitsschädlichen Keimen befallen als bislang angenommen.
So wiesen die über 22.000 zwischen 2003 und 2009 untersuchten Proben in mehr als 13% der Fälle eine erhöhte Konzentration von Legionellen auf, und knapp 3% enthielten sogar den Erreger Pseudomonas aeruginosa. Darüber hinaus lauern gerade in Kliniken und Krankenhäusern weitere gefährliche Viren und Bakterien wie etwa MRSA (Methicillin-resistenter Staphylococcus aureus), die nicht in die Trinkwasserinstallation gelangen dürfen. Daher sind bei der Planung einer neuen oder der Sanierung einer bereits bestehenden Anlage einige wichtige Aspekte zu beachten.
Auf Keimherde achten
Die größte Herausforderung für Hygieniker und Techniker liegt in der Kontrolle der beiden möglichen Keimherde: des Trinkwassers selbst und der mit Mikroorganismen besiedelten Rohr- bzw. Wandfläche eines Leitungssystems. Dabei bilden die Organismen bevorzugt auf rauen zerklüfteten Oberflächen, wie beispielsweise auf Verkrustungen in Rohren, oder in schlammartigen Ablagerungen in Warmwasserbereitern einen schleimförmigen Biofilm, der sich aus miteinander verbunden Kolonien von Organismen sowie abgestorbenen Zellen und anorganischen Teilen zusammensetzt. Diesen Biofilmen genügen zu Entstehung und Wachstum bereits minimale Mengen verwertbaren organischen Materials. So bilden beispielsweise Kalkausfällungen einen idealen Nährboden für Keime.
Stagnation ausschließen
Die Gründe für erhöhte Keimzahlen im Trinkwasser öffentlicher Gebäude sind vor allem technischer Natur: Häufige An- und Umbauten, überdimensionierte Rohrleitungssysteme mit geringer Wasserdurchströmung sowie zu groß bemessene Warmwasserbereiter oder die mangelhafte Enthärtung und Dosierung des Wassers begünstigen die Keimbildung in der Trinkwasserinstallation. Zu den weiteren Ursachen gehören auch fehlende oder nicht gewartete Filter, obwohl deren Einbau und Kontrolle nach DIN 1988 Pflicht sind. Zudem sollte über einen bestimmungsgemäßen Betrieb der Anlage insgesamt, die Vermeidung von Stagnationswasser oberstes Prinzip sein. Denn es gilt der Grundsatz: Fließendes Wasser kann nicht verkeimen.
Einfache Regeln reduzieren das Risiko der Keimbildung
In der Tat liegen die wichtigsten Anforderungen an eine sichere und keimfreie Trinkwasserinstallation bereits in schriftlicher Form vor. So definiert etwa die Trinkwasserverordnung (TrinkwV 2001) sowohl den Rahmen für das Trinkwasser Kalt als auch für das Trinkwasser Warm. Die Verpflichtungen aus der TrinkwV 2001 bedeuten in der Praxis, dass die Trinkwassersysteme nach den gültigen Gesetzen, Normen und Richtlinien zu planen, auszuführen, zu betreiben und instand zu halten sind. Für alle Trinkwasserinstallationen gilt darüber hinaus das Arbeitsblatt DVGW W551 bei Planung, Bau und Betrieb, Überwachung und Sanierung.
Grundsätzlich lässt sich die Gefahr einer Verkeimung bei vorsorglicher Beachtung bestimmter Faktoren in Betrieb und Bau reduzieren. Dazu zählen u. a. die Vermeidung von Tot- oder Stichleitungen sowie der Verzicht auf lange und weitverzweigte Trinkwassersysteme. Konstruktiv leisten vor allem durchgeschliffene Reihen- und Ringleitungen einen Beitrag zum Erhalt der Trinkwassergüte, da bei bestimmungsgemäßem Betrieb das Wasser hier regelmäßig und vollständig ausgetauscht wird. In Kombination mit einem System zur automatischen Auslösung ist dieser Effekt selbst bei längeren Nutzungsunterbrechungen gesichert.
Daneben sollten Kalt- und Warmwasserleitungen nach EnEV 2009 gedämmt werden, um eine Erwärmung im Kaltwasser bzw. eine Abkühlung im Warmwasser zu vermeiden und damit das Wachstum von Keimen zu bremsen. Für Trinkwasser-Warm-Systeme ist die Betriebstemperatur über 55 °C innerhalb des Leitungssystems einzuhalten, während gleichzeitig eine stetige Durchströmung gewährleistet sein muss. Für Trinkwasser-Kalt-Systeme ist die maximale Temperatur von 25 °C einzuhalten.
Technik sichert Trinkwasserhygiene
Um eine Verkeimung des Trinkwassers zu verhindern, bedient man sich in der Praxis unterschiedlicher Methoden. Zunächst sollte eine Überdimensionierung der Trinkwasserinstallation vermieden werden, indem zwar die Empfehlungen der DIN-Normen berücksichtigt werden, aber im Einzelfall vor allem das spätere Nutzerverhalten im Vordergrund steht. So ist beispielsweise in Krankenhäusern eine Aufteilung der Installation in separate, kleinere Versorgungseinheiten eine sinnvolle Lösung. Die Steuerung dieser Einheiten kann dann über intelligente Wassermanagementsysteme erfolgen. Sie können beispielsweise nachträgliche Spülungen bei Verbrauchsunterbrechungen auslösen oder als regelmäßige Hygienespülungen gegen Stagnationswasser zugleich zeit- und temperaturgesteuerte thermische Desinfektionen ermöglichen. Bei diesem Verfahren wird gemäß dem DVGW Arbeitsblatt W 551 jede Zapfstelle für drei Minuten mit 70 °C heißem Wasser durchspült, um eventuell vorhandene Mikroorganismen abzutöten und zu entfernen.
Durch chemische Desinfektion kann Bakterienbefall in der Trinkwasserin¬stallation ebenfalls reduziert werden. Zu berücksichtigen sind dabei die Vorschriften nach § 6 und § 11 der TrinkwV 2001, um eventuelle Belastungen der Trinkwassergüte wie der Trinkwasseranlage zuverlässig auszuschließen. Als weitere Alternative zur thermisch-chemischen Desinfektion haben sich in jüngster Zeit die UV- und Membrantechnik entwickelt. So inaktivieren UV-Geräte durch Bestrahlung mit UV-Licht (bei einer Wellenlänge von 254 Nanometern) die Mikroorganismen und beugen damit - vor allem in Verbindung mit Ultraschall - deren Vermehrung vor. Einen anderen, ebenfalls umweltfreundlichen Weg geht die Mem¬brantechnik, die Bakterien und Viren mittels sehr kleiner Poren (< 0,2 Nanometer) aus dem Wasser filtert.
Trinkwasserhygiene muss Priorität besitzen
Gerade in Krankenhäusern kann in der Trinkwasserinstallation neben Legionellen und Pseudomonaden eine Vielzahl weiterer pathogener Bakterien, Viren und Pilze auftreten, die das Trinkwasser negativ beeinflussen. Obwohl umfassende gesetzliche Regelungen zur Trinkwasserhygiene ebenso vorhanden sind wie wirksame technische Lösungen, fehlt häufig die konsequente Umsetzung und Überwachung in der Praxis. Darüber hinaus erfordert die dauerhafte Sicherung der Trinkwasserhygiene die Zusammenarbeit aller für Planung, Ausführung und Überwachung von Trinkwasserinstallationen Verantwortlichen und sollte nicht mit der Übergabe der Anlage enden. Denn nur eine nach den anerkannten Regeln der Technik geplante, installierte und gewartete Anlage garantiert die Sicherheit sauberen Trinkwassers in Krankenhäusern.









